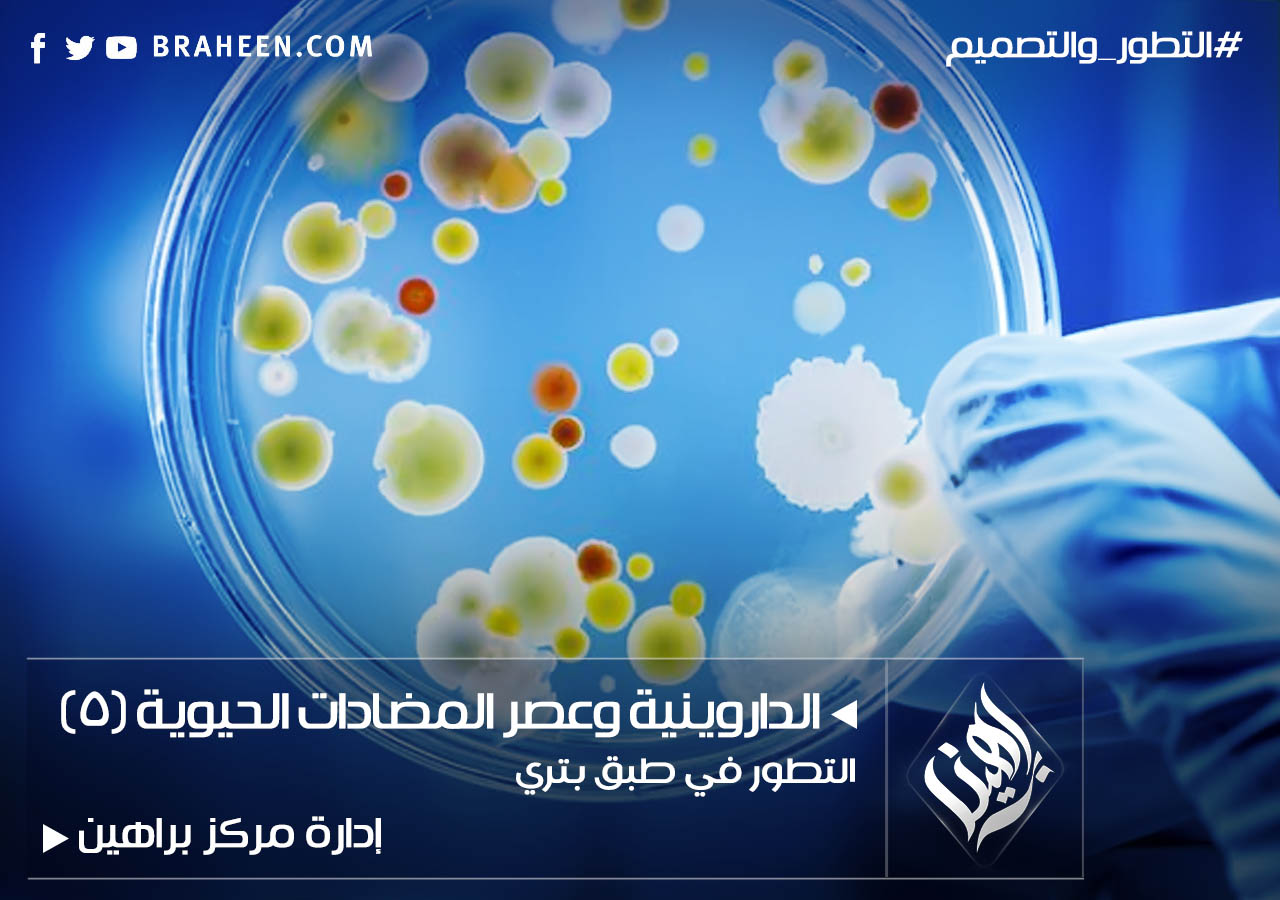

- مايو 2018
- تأليف: د. ستيفن ماير
مايو 2018
- مايو 2018
- تأليف: د. ستيفن ماير
مايو 2018
- مايو 2018
- مايو 2018
- إبريل 2018
- تأليف: إدارة مركز براهين
يناير 2018
- تأليف: إدارة مركز براهين
يناير 2018
- تأليف: إدارة مركز براهين
يناير 2018
- يناير 2018
- يناير 2018
للتواصل معنا
وسيلة الاتصال الرئيسية بالمركز هي عبر البريد الرسمي للاستفسارات والأسئلة العامة info@braheen.com ويمكنكم أيضا التواصل معنا عبر صفحة الفيسبوك أو عبر نموذج الاتصال في الموقع.
إصداراتنا
يعمل المركز على خطة ترجمة وتأليف طويلة الأمد، في محاولة لسد النقص في المواد اللازمة للباحثين في مجال نقد الإلحاد واللادينية، والقضايا العلمية والفلسفية ذات الصلة. للمزيد يرجى زيارة صفحة إصداراتنا.
من نحن؟!
مركز براهين للأبحاث والدراسات هو مركز بحثي مستقل لا يتبع لأي جهة أو حزب أو جماعة، والآراء الواردة في الموقع لا تعبر بالضرورة عن رأي المركز ولكن بالأصالة عن رأي كتابها، للمزيد يرجى زيارة صفحة عن المركز.
جميع الحقوق محفوظة © مركز براهين للأبحاث والدراسات 2020